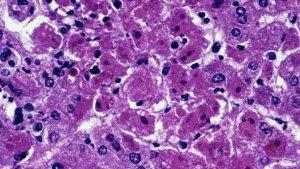
Penyakit-virus-Marburg.jpg

Informasi Awal #
TRIBUNNEWSWIKI.COM - Komodo dikenal dunia dengan sebutan Komodo Dragon (Naga Komodo).
Komodo memiliki habitat asli di Pulau Komodo, Kabupaten Manggarai Barat, Provinsi Nusa Tenggara Timur ( NTT ).
Komodo (Varanasus Komodoensis) merupakan spesies kadal yang juga merupakan salah satu hewan endemik Indonesia.
Keunikan #
Tahukah kamu bahwa ternyata Komodo memiliki keunikan dan keistimewaan seperti berikut:
1. Komodo merupakan Hewan Purbakala.
Komodo sudah ada sejak 25-40 tahun yang lalu dan merupakan kerabat dekat dari Dinosaurus, hal ini dapat dilihat dari kemiripan komodo dengan beberapa fosil Dinosaurus. Komodo sering disebut-sebut sebagai "Dinosaurus Terakhir di Dunia"
2. Menghabiskan Waktunya di Pohon.
Komodo muda banyak menghabiskan waktu di pohon. Pohon merupakan tempat bersembunyi yang cukup aman untuk menghindari para predator dan komodo kanibal.
3. Komodo makan sekali sebulan
Komodo memangsa langsung makanannya (seperti Kijang, Kerbau, dsb) tanpa mengunyahnya, setelah memakannya komodo dapat beristirahat selama 1 bulan penuh tanpa makan sedikitpun.

4. Komodo kecil hanya Memakan Serangga
Anak Komodo belum mampu memakan hewan-hewan yang berukuan besar seperti kijang. Mereka hanya memakan serangga seperti belalang.
5. Proses Pencernaan Komodo dibantu Sinar Matahari
Setelah makan biasanya komodo membawa dirinya untuk mencari sinar matahari yang berfungsi untuk mempercepat proses pencernaannya.
6. Komodo Merupakan Kadal Terbesar di Dunia
Komodo adalah kadal terbesar di dunia, dengan panjang 2 sampai 3 meter.
7. Komodo Hidup lebih dari 50 Tahun
Komodo Jantan dapat Hidup Lebih dari 50 Tahun dan usia tersebut tergolong sangat panjang untuk spesies kadal. Sedangkan Komodo betina umumnya hanya hidup hingga usia 31 tahun.
8. Perbedaan Komodo Jantan dan Betina
Komodo jantan lebih besar daripada komodo betina, dengan warna kulit dari abu-abu gelap sampai merah batu bata, sementara komodo betina biasanya berwarna hijau kecokelatan dan memiliki bercak kecil kuning pada tenggorokannya. Komodo muda lebih bervariasi warnanya, dengan warna kuning, hijau dan putih dengan latar belakang hitam.
9. Komodo Berkembangbiak tanpa Pejantan
Dengan kemampuan inilah komodo dapat bertahan dari ancaman kepunahan. Namun perkembangbiakan seperti ini hanya akan menghasilkan komodo jantan.
10. Perbandingan Jumlah Komodo Jantan dengan Komodo Betina adalah 3:1
Beberapa komodo betina melakukan perkembiakan tanpa adanya pejantan, sehingga komodo yang dihasilkan sudah pasti merupakan komodo jantan.
Baca: Pulau Komodo
11. Musim Kawin, 3 Komodo Jantan Memperebutkan 1 Komodo Betina
Karena perbedaan populasi pejantan dan betinanya, Komodo jantan harus saling berkelahi untuk mendapatkan 1 komodo betina.
Saat bertarung umumnya komodo hanya berdiri menggunakan kedua kaki belakangnya saja.
12. Musim kawin komodo biasanya berlangsung antara bulan Mei hingga Agustus.
Selama periode ini, komodo jantan sering berkelahi dengan pejantan lain untuk memperebutkan betina dan wilayah kekuasaannya.
Dua pejantan "bergulat" dengan jantan lainnya sambil berdiri menggunakan kaki belakang lalu saling mendorong dan memukul dengan kaki depan. Komodo yang kalah akan terjatuh dan "terkunci" ke tanah. Kedua komodo jantan itu dapat muntah atau buang air besar ketika bersiap untuk berkelahi.
Pemenang pertarungan akan menjulurkan lidah panjangnya pada tubuh si betina untuk melihat penerimaan sang betina. Komodo betina bersifat antagonis dan melawan dengan gigi dan cakar mereka selama awal fase berpasangan.
Selanjutnya, jantan harus sepenuhnya mengendalikan betina selama bersetubuh agar tidak terluka.Selama perkawinan, si jantan menggosokkan dagu mereka pada si betina, disertai garukan keras di atas punggung dan menjilat.
13. Komodo betina biasanya meletakkan telurnya di lubang tanah.
Cekungan di tebing bukit atau gundukan sarang burung gosong berkaki-jingga yang telah ditinggalkan. Akan tetapi, komodo lebih suka menyimpan telur-telurnya di sarang yang telah ditinggalkan.
14. Sarang komodo rata-rata berisi 20 telur.
Betina berbaring di atas telur-telur itu untuk mengerami dan melindunginya sampai menetas setelah dierami selama 7–8 bulan.
15. Proses penetasan
Proses penetasan adalah usaha melelahkan untuk anak komodo, yang keluar dari cangkang telur setelah menyobeknya dengan gigi telur yang akan tanggal setelah pekerjaan berat ini selesai.
Setelah berhasil menyobek kulit telur, bayi komodo dapat berbaring di cangkang telur mereka untuk beberapa jam sebelum mulai menggali keluar sarang mereka. Ketika menetas, bayi-bayi ini sangat rentan dimangsa oleh predator.
16. Banyak Anak Komodo tak bisa bertahan
Tingkat kelahiran komodo bisa mencapai angka 85%, akan tetapi tingkat bertahan hidup anak komodo di alam hanya sekitar 10-15%.
17. Komodo bikin 2 Lubang Palsu
Komodo umumnya menggali lubang sedalam 2 meter untuk meletakan telur-telurnya. Untuk menghindari pemangsa, komodo biasanya membuat 2 lubang palsu.
18. Komodo adalah Binatang Soliter
Beberapa hewan bekerjasama untuk mendapatkan makanan, tapi tidak dengan komodo. Komodo mencari makanannya sendiri dan sering berebut makanan.
19. Lidah Komodo Mirip dengan Lidah Ular
Tidak hanya bentuknya fungsi lidah komodopun juga mirip dengan ular, yaitu dapat mengikuti jejak aroma dengan lidah.
20. Liur Komodo Sangatlah Berbahaya
Di dalam liur komodo terdapat puluhan bakteri yang mematikan. Air liur komodo merupakan salah satu hal yang sering dibicarakan banyak orang.
Karena kebanyakan orang menganggapnya beracun seperti bisa ular atau kadal beracun, bahkan dianggap tidak ada obatnya, baik untuk mencegah maupun menetralkan racun tersebut.
21. Hukum Rimba
Komodo yang lebih besar biasanya akan makan terlebih dahulu dibanding komodo yang berukuran lebih kecil. Sedangkan komodo yang berukuran sama akan berkelahi terlebih dulu untuk memperebutkan makanannya.
Baca: Labuan Bajo, Kecamatan Komodo
22. Komodo dapat Berlari dengan Kecepatan 20 km/jam
Kecepatan tersebut tergolong cukup cepat untuk seekor reptil.
23. Komodo Tidak dapat berlari Secara Zig-Zag
Saat komodo mengejar manusia, komodo seharusnya dapat menangkap manusia dengan mudah. Akan tetapi umumnya seseorang yang dikejar komodo mengakalinya dengan berlari secara zig-zag, dengan begitu komodo akan bingung dan menghambat pergerakan komodo.
24. New Seven Wonders of Nature
Sekitar tahun 2011 lalu, Taman Nasional Komodo ( TNK ) yang ada di Kabupaten Manggarai Barat, Provinsi Nusa Tenggara Timur ( NTT ) pernah masuk sebagai finalis dalam ajang pemilihan tujuh keajaiban alam baru atau New Seven Wonders of Nature (N7WN). Sebab TNK memiliki hewan purbakala bernama Komodo.

25. Komodo di NTT
Komodo, atau juga disebut biawak komodo (Varanus komodoensis), adalah spesies biawak besar yang terdapat di Pulau Komodo, Rinca, Flores, Gili Motang, dan Gili Dasami di Provinsi Nusa Tenggara Timur, Indonesia. Biawak ini oleh penduduk asli pulau Komodo juga disebut dengan nama setempat ora.
Komodo liar hanya terdapat dan hanya bisa ditemukan di Indonesia di Nusa Tenggara Timur, tepatnya di pulau Komodo, Rinca dan beberapa pulau kecil di sekitarnya serta di pesisir barat pulau Flores.
26. Komodo Dewasa
Komodo dewasa lebih liar dewasa biasanya memiliki berat sekitar 70 kg, tetapi komodo yang dipelihara di penangkaran sering kali memiliki bobot yang lebih berat.
Spesimen liar terbesar yang pernah ditemukan panjangnya mencapai 3.13 meter dengan berat sekitar 166 kg, termasuk berat makanan yang belum dicerna di dalam perutnya.
27. Komodo memiliki ekor yang sama panjang dengan tubuhnya.
Meskipun komodo tercatat sebagai kadal terbesar di dunia, namun bukan spesies yang terpanjang. Reputasi panjang tubuh (tidak termasuk berat badan) dipegang oleh biawak Papua (Varanus salvadorii).
28. Gigi Komodo
Di dalam mulut komodo dewasa, terdapat sekitar 60 buah gigi yang bergerigi tajam sepanjang sekitar 2.5 cm, yang sering terlepas atau ditanggalkan. Komodo memiliki lidah yang panjang, berwarna kuning kecokelatan dan bercabang.
29. Penglihatan Komodo
Komodo mampu melihat hingga sejauh 300 m, namun karena retinanya hanya memiliki sel kerucut, hewan ini tidak dapat melihat dengan baik di kegelapan malam.
Komodo mampu membedakan warna namun tidak begitu mampu membedakan objek yang tak bergerak. Komodo tidak memiliki indera pendengaran, walaupun memiliki lubang telinga.
30. Mencium Mangsa
Komodo menggunakan lidahnya untuk mencium bau mangsanya seperti halnya sebagian besar Squamata. Lidah komodo menangkap partikel bau di udara lalu menaruhnya ke organ di langit-langit mulutnya yang disebut organ Jacobson yang berfungsi untuk menganalisis tanda-tanda dari bau tersebut.
31. Manfaat Lubang Hidung Komodo
Dengan bantuan angin dan kebiasaannya menolehkan kepalanya ke kanan dan ke kiri ketika berjalan, komodo dapat mendeteksi keberadaan daging bangkai sejauh 4—9.5 km. Lubang hidung komodo hanya berfungsi untuk bernafas dan bukan mencium bau karena komodo tidak memiliki selaput penerima bau di hidungnya.
32. Organ perasa Komodo
Komodo juga tidak memiliki organ perasa di lidahnya, hanya ada sedikit ujung-ujung saraf perasa di tenggorokan dalam.
33. Komodo Tuli
Komodo sempat dianggap tuli ketika penelitian mendapatkan bahwa bisikan, suara yang meningkat dan teriakan ternyata tidak memengaruhi komodo tersebut. Hal ini kemudian terbantahkan ketika karyawan Kebun Binatang London ZSL, Joan Proctor melatih biawak komodo untuk keluar makan dengan suaranya, bahkan juga ketika ia tidak terlihat oleh si biawak.
34. Komodo Cepat Berlari
Komodo adalah binatang yang penyendiri dan hanya berkumpul bersama pada saat makan atau berkembang biak. Biawak ini dapat berlari cepat hingga 20 km/jam pada jarak yang pendek.
35. Komodo Pandai Berenang
juga pandai berenang dan mampu menyelam sedalam 4.5 meter serta pandai memanjat pohon menggunakan cakar mereka yang kuat. Untuk menangkap mangsa yang berada di luar jangkauannya, komodo dapat berdiri dengan kaki belakangnya dan menggunakan ekornya sebagai penunjang.
36. Komodo Suka Makan Daging Bangkai
Komodo adalah hewan pemakan hewan lain (karnivora). Akan tetapi, biawak ini lebih sering memakan daging bangkai. Penelitian yang ada menunjukkan bahwa biawak komodo berburu mangsa hidup dengan cara mengendap-endap diikuti dengan serangan tiba-tiba terhadap korbannya.
Ketika mangsa itu sudah dalam jangkauannya, komodo segera menyerangnya dengan menggigit pada sisi bawah tubuh atau tenggorokan. Komodo menemukan mangsanya dengan menggunakan lidahnya yang dapat merasakan bau mangsa, binatang mati atau sekarat pada jarak hingga 9,5 kilometer.
37. Berjemur setelah makan
Setelah makan, komodo berjalan menyeret tubuhnya yang kekenyangan mencari tempat terbuka untuk berjemur dan mempercepat proses pencernaan. Kalau tidak, makanan itu dapat membusuk dalam perutnya dan meracuni tubuhnya sendiri.
Dikarenakan metabolismenya yang lamban, komodo besar dapat bertahan dengan hanya makan kira-kira 12 kali setahun atau sekali sebulan.
Setelah daging mangsanya tercerna, komodo memuntahkan sisa-sisa tanduk, rambut dan gigi mangsanya, dalam gumpalan-gumpalan bercampur dengan lendir berbau busuk. Kemudian, komodo menyapukan wajahnya ke tanah atau ke semak-semak untuk membersihkan sisa-sisa lendir yang masih menempel di mulutnya.
38. Cara Makan Komodo
Ketika makan secara berkelompok, komodo yang berukuran paling besar biasanya makan terlebih dahulu, diikuti dengan komodo lain yang berukuran lebih kecil.
Jantan terbesar menunjukkan dominasinya melalui bahasa tubuh dan desisannya, yang kemudian disambut dengan bahasa yang sama oleh jantan-jantan lain yang lebih kecil untuk memperlihatkan pengakuan mereka atas kekuasaan komodo besar itu.
Komodo-komodo yang berukuran sama mungkin akan berkelahi mengadu kekuatan, dengan cara berdiri pada dua kaki belakang, lalu saling memukul dan mendorong dengan kaki depan, hingga salah satu mengaku kalah dan mundur walau kadang yang kalah dapat terbunuh dalam perkelahian dan dimangsa oleh si pemenang.
39. Menggali Kuburan
Kadang-kadang komodo juga memangsa manusia dan mayat yang digali dari lubang makam yang dangkal. Kebiasaan ini menyebabkan penduduk pulau Komodo menghindari tanah berpasir dan memilih mengubur jenazah di tanah liat, serta menutupi atasnya dengan batu-batu agar tidak dapat digali oleh komodo.
40. Betina Bisa Berkembangbiak tanpa pejantan
Di samping proses reproduksi yang normal, terdapat beberapa contoh kasus komodo betina menghasilkan anak tanpa kehadiran pejantan (partenogenesis), fenomena yang juga diketahui muncul pada beberapa spesies reptil lainnya seperti pada Cnemidophorus.
(Tribunnewswiki.com)